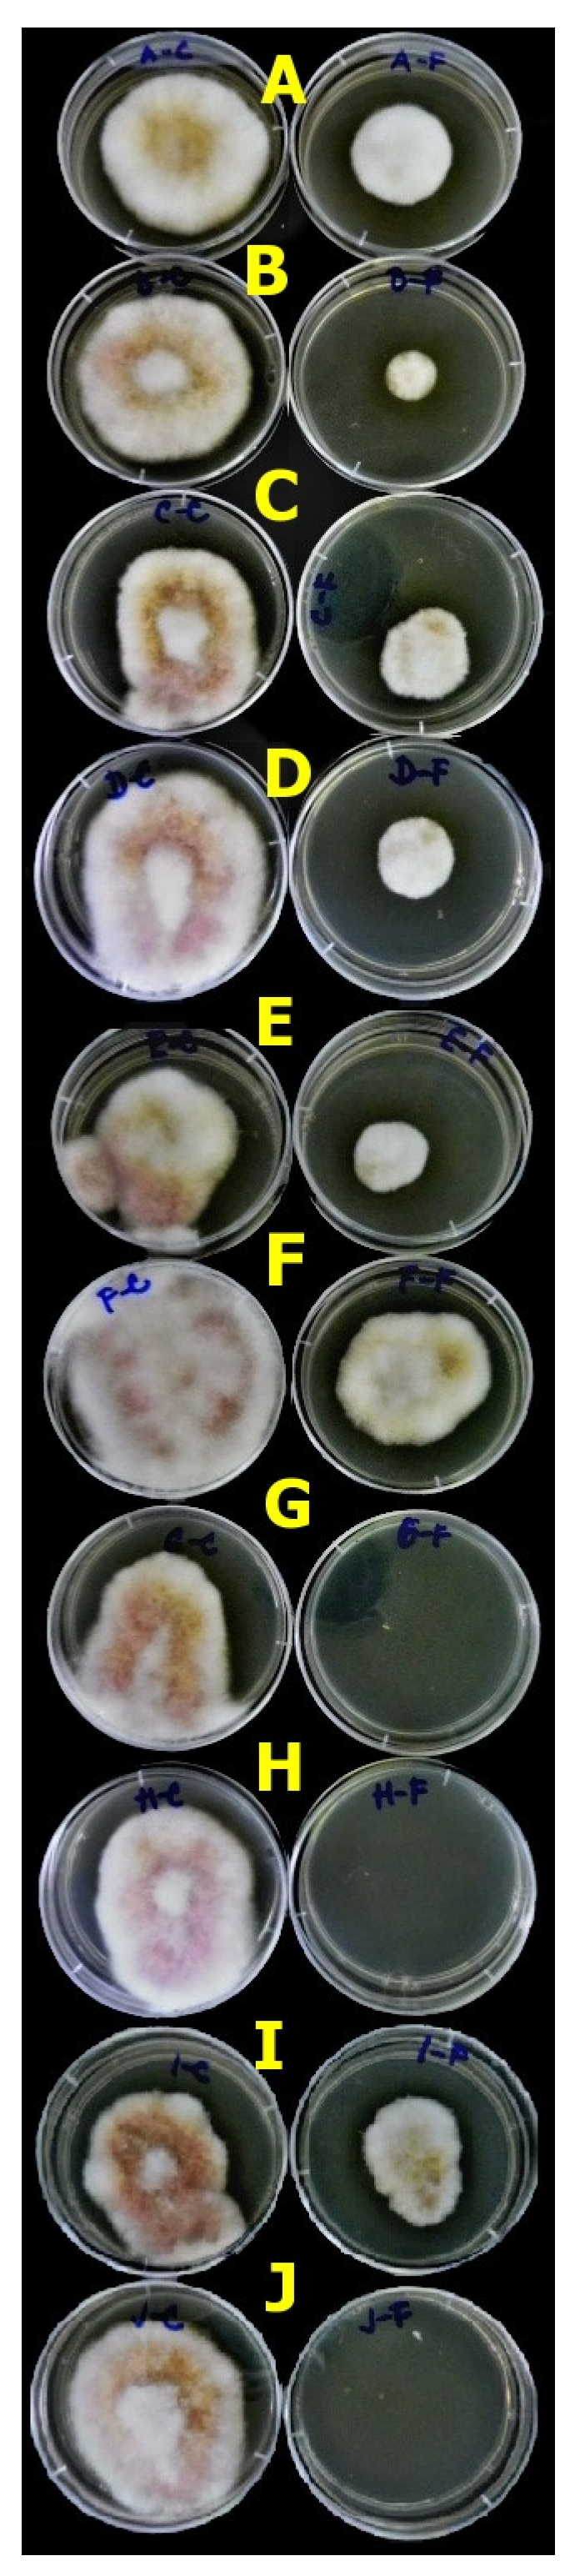
Agronomy 13 02911 g006
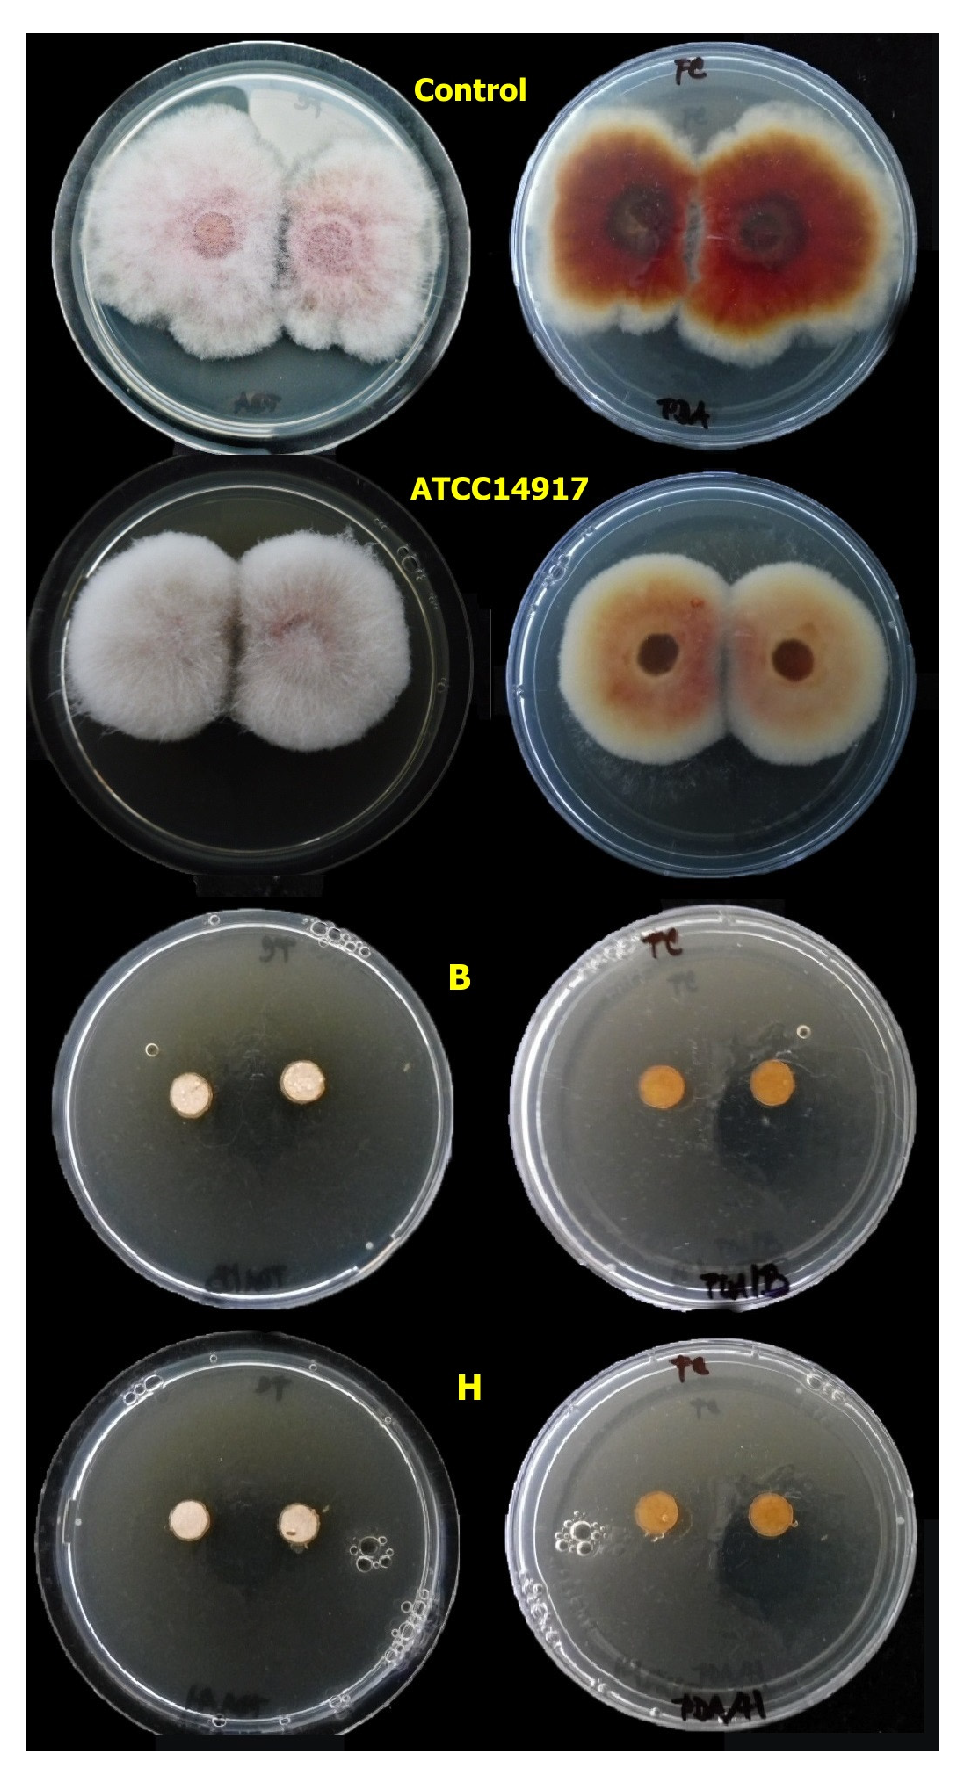
Agronomy 13 02911 g007

Characterisation of Wild Strains of Lactic Acid Bacteria Isolated from Legumes and Their Biocontrol Potential against Fusarium spp.
Abstract
:1. Introduction
2. Materials and Methods
2.1. Isolation and Identification of LAB
2.2. Isolation and Identification of Fusaria
2.3. Functional Characteristics of Lactobacilli
2.3.1. PCR Amplification of Class IIa Bacteriocin Genes
2.3.2. PCR Amplification of the Chitinase Gene
2.3.3. Chitinase Production
2.3.4. Production of Organic Acids
2.4. Antifungal Assays
2.4.1. Agar Plug Diffusion Method
2.4.2. Antifungal Activity of Extracellular Products
2.5. Data Processing
3. Results and Discussion
3.1. Isolation and Identification of LAB
3.2. Isolation and Identification of Fusarium spp.
3.3. Functional Characteristics of Lactobacilli
3.3.1. Bacteriocin Gene Class IIa
3.3.2. Chitinase Genes and Extracellular Chitinase Production
3.3.3. Production of Organic Acids
3.4. Antifungal Assays
3.4.1. Agar Plug Assay
3.4.2. Mycelia Growth
4. Conclusions
Supplementary Materials
Author Contributions
Funding
Data Availability Statement
Acknowledgments
Conflicts of Interest
References
- Wille, L.; Messmer, M.M.; Studer, B.; Hohmann, P. Insights to plant–microbe interactions provide opportunities to improve resistance breeding against root diseases in grain legumes. Plant Cell Environ. 2019, 42, 20–40. [Google Scholar] [CrossRef]
- Arie, T. Fusarium diseases of cultivated plants, control, diagnosis, and molecular and genetic studies. J. Pestic. Sci. 2019, 44, 275–281. [Google Scholar] [CrossRef]
- Sampaio, A.M.; De Sousa Araújo, S.; Rubiales, D.; Patto, M.C.V. Fusarium wilt management in legume crops. Agronomy 2020, 10, 1073. [Google Scholar] [CrossRef]
- Lahlali, R.; Ezrari, S.; Radouane, N.; Kenfaoui, J.; Esmaeel, Q.; El Hamss, H.; Belabess, Z.; Barka, E.A. Biological Control of Plant Pathogens: A Global Perspective. Microorganisms 2022, 10, 596. [Google Scholar] [CrossRef]
- Duar, R.M.; Lin, X.B.; Zheng, J.; Martino, M.E.; Grenier, T.; Pérez-Muñoz, M.E.; Leulier, F.; Gänzle, M.; Walter, J. Lifestyles in transition: Evolution and natural history of the genus Lactobacillus. FEMS Microbiol. Rev. 2017, 41, 27–48. [Google Scholar] [CrossRef]
- Oberg, T.S.; McMahon, D.J.; Culumber, M.D.; McAuliffe, O.; Oberg, C.J. Invited review: Review of taxonomic changes in dairy-related lactobacilli. J. Dairy Sci. 2022, 105, 2750–2770. [Google Scholar] [CrossRef]
- Zheng, J.; Wittouck, S.; Salvetti, E.; Franz, C.M.A.P.; Harris, H.M.B.; Mattarelli, P.; O’toole, P.W.; Pot, B.; Vandamme, P.; Walter, J.; et al. A taxonomic note on the genus Lactobacillus: Description of 23 novel genera, emended description of the genus Lactobacillus beijerinck 1901, and union of Lactobacillaceae and Leuconostocaceae. Int. J. Syst. Evol. Microbiol. 2020, 70, 2782–2858. [Google Scholar] [CrossRef]
- Enebe, M.C.; Babalola, O.O. The impact of microbes in the orchestration of plants’ resistance to biotic stress: A disease management approach. Appl. Microbiol. Biotechnol. 2019, 103, 9–25. [Google Scholar] [CrossRef]
- Lamont, J.R.; Wilkins, O.; Bywater-Ekegärd, M.; Smith, D.L. From yoghurt to yield: Potential applications of lactic acid bacteria in plant production. Soil Biol. Biochem. 2017, 111, 1–9. [Google Scholar] [CrossRef]
- Raman, J.; Kim, J.S.; Choi, K.R.; Eun, H.; Yang, D.; Ko, Y.J.; Kim, S.J. Application of Lactic Acid Bacteria (LAB) in Sustainable Agriculture: Advantages and Limitations. Int. J. Mol. Sci. 2022, 23, 7724. [Google Scholar] [CrossRef]
- Di Cagno, R.; De Angelis, M.; Calasso, M.; Vincentini, O.; Vernocchi, P.; Ndagijimana, M.; De Vincenzi, M.; Dessi, M.R.; Guerzoni, M.E.; Gobbetti, M. Quorum sensing in sourdough Lactobacillus plantarum DC400: Induction of plantaricin a (PlnA) under co-cultivation with other lactic acid bacteria and effect of PlnA on bacterial and Caco-2 cells. Proteomics 2010, 10, 2175–2190. [Google Scholar] [CrossRef]
- Ruiz Rodríguez, L.G.; Mohamed, F.; Bleckwedel, J.; Medina, R.; De Vuyst, L.; Hebert, E.M.; Mozzi, F. Diversity and functional properties of lactic acid bacteria isolated from wild fruits and flowers present in northern Argentina. Front. Microbiol. 2019, 10, 1091. [Google Scholar] [CrossRef]
- Yu, A.O.; Leveau, J.H.J.; Marco, M.L. Abundance, diversity and plant-specific adaptations of plant-associated lactic acid bacteria. Environ. Microbiol. Rep. 2020, 12, 16–29. [Google Scholar] [CrossRef]
- Yu, A.O.; Goldman, E.A.; Brooks, J.T.; Golomb, B.L.; Yim, I.S.; Gotcheva, V.; Angelov, A.; Kim, E.B.; Marco, M.L. Strain diversity of plant-associated Lactiplantibacillus plantarum. Microb. Biotechnol. 2021, 14, 1990–2008. [Google Scholar] [CrossRef]
- Kavková, M.; Cihlář, J.; Dráb, V.; Bazalová, O.; Dlouhá, Z. The Interactions among Isolates of Lactiplantibacillus plantarum and Dairy Yeast Contaminants: Towards Biocontrol Applications. Fermentation 2022, 8, 14. [Google Scholar] [CrossRef]
- Palla, M.; Cristani, C.; Giovannetti, M.; Agnolucci, M. Large genetic intraspecific diversity of autochthonous lactic acid bacteria and yeasts isolated from PDO Tuscan bread sourdough. Appl. Sci. 2020, 10, 1043. [Google Scholar] [CrossRef]
- Behera, S.S.; Ray, R.C.; Zdolec, N. Lactobacillus plantarum with Functional Properties: An Approach to Increase Safety and Shelf-Life of Fermented Foods. BioMed Res. Int. 2018, 2018, 9361614. [Google Scholar] [CrossRef]
- Bergsma, S.; Euverink, G.J.W.; Charalampogiannis, N.; Poulios, E.; Janssens, T.K.S.; Achinas, S. Biotechnological and Medical Aspects of Lactic Acid Bacteria Used for Plant Protection: A Comprehensive Review. BioTech 2022, 11, 40. [Google Scholar] [CrossRef]
- Ristić, D.; Vucurović, I.; Aleksić, G.; Nikolić, B.; Djurović, S.; Starović, M. Application of different combinations of lactic acid, phototrophic bacteria and yeast mixtures in control of seed and seedlings pathogens of tomato and pepper. Pestic. i Fitomedicina 2021, 36, 73–82. [Google Scholar] [CrossRef]
- Steglińska, A.; Kołtuniak, A.; Motyl, I.; Berłowska, J.; Czyżowska, A.; Cieciura-Włoch, W.; Okrasa, M.; Kręgiel, D.; Gutarowska, B. Lactic Acid Bacteria as Biocontrol Agents against Potato (Solanum tuberosum L.) Pathogens. Appl. Sci. 2022, 12, 7763. [Google Scholar] [CrossRef]
- Balouiri, M.; Sadiki, M.; Ibnsouda, S.K. Methods for in vitro evaluating antimicrobial activity: A review. J. Pharm. Anal. 2016, 6, 71–79. [Google Scholar] [CrossRef] [PubMed]
- Hamilton-Miller, J.M.T.; Shah, S. Comparative in-vitro activity of ketolide HMR 3647 and four macrolides against Gram-positive cocci of known erythromycin susceptibility status. J. Antimicrob. Chemother. 1998, 61, 649–653. [Google Scholar] [CrossRef] [PubMed]
- Samson, R.A.; Houbraken, J.; Thrane, U.; Frisvad, J.C.; Andersen, B. Food and Indoor Fungi, 1st ed.; Crous, P.W., Samson, R.A., Eds.; CBS-KNAW Fungal Biodiversity Centre Utrecht: Utrecht, The Netherlands, 2010; p. 390. [Google Scholar]
- Schoch, C.L.; Seifert, K.A.; Huhndorf, S.; Robert, V.; Spouge, J.L.; Levesque, C.A.; Chen, W.; Bolchacova, E.; Voigt, K.; Crous, P.W.; et al. Nuclear ribosomal internal transcribed spacer (ITS) region as a universal DNA barcode marker for Fungi. Proc. Natl. Acad. Sci. USA 2012, 109, 6241–6246. [Google Scholar] [CrossRef] [PubMed]
- Boutigny, A.L.; Gautier, A.; Basler, R.; Dauthieux, F.; Leite, S.; Valade, R.; Aguayo, J.; Ioos, R.; Laval, V. Metabarcoding targeting the EF1 alpha region to assess fusarium diversity on cereals. PLoS ONE 2019, 14, e0207988. [Google Scholar] [CrossRef] [PubMed]
- Kavková, M.; Cihlář, J.; Dráb, V.; Bár, L. Differentiation of Penicillium roqueforti from closely related species contaminating cheeses and dairy environment. Fermentation 2021, 7, 222. [Google Scholar] [CrossRef]
- Wang, Y.; Wu, J.; Lv, M.; Shao, Z.; Hungwe, M.; Wang, J.; Bai, X.; Xie, J.; Wang, Y.; Geng, W. Metabolism Characteristics of Lactic Acid Bacteria and the Expanding Applications in Food Industry. Front. Bioeng. Biotechnol. 2021, 9, 612285. [Google Scholar] [CrossRef]
- Wieckowicz, M.; Schmidt, M.; Sip, A.; Grajek, W. Development of a PCR-based assay for rapid detection of class IIa bacteriocin genes. Lett. Appl. Microbiol. 2011, 52, 281–289. [Google Scholar] [CrossRef]
- Liu, P.; Cheng, D.; Miao, L. Characterization of thermotolerant chitinases encoded by a Brevibacillus laterosporus strain isolated from a suburban wetland. Genes 2015, 6, 1268–1282. [Google Scholar] [CrossRef]
- Haider, S.R.; Reid, J.H.; Sharp, B.L. Tricine-SDS-PAGE. In Protein Electrophoresis: Methods in Molecular Biology; Kurien, B.T., Hal Scofield, R., Eds.; Humana Press: Totowa, NJ, USA, 2012; Volume 869, pp. 81–91. [Google Scholar] [CrossRef]
- Demirbaş, F.; İspirli, H.; Kurnaz, A.A.; Yilmaz, M.T.; Dertli, E. Antimicrobial and functional properties of lactic acid bacteria isolated from sourdoughs. LWT Food Sci Technol. 2017, 79, 361–366. [Google Scholar] [CrossRef]
- Matchado, M.S.; Lauber, M.; Reitmeier, S.; Kacprowski, T.; Baumbach, J.; Haller, D.; List, M. Network analysis methods for studying microbial communities: A mini-review. Comp. Struct. Biotech. J. 2021, 19, 2687–2698. [Google Scholar] [CrossRef]
- Martino, M.E.; Bayjanov, J.R.; Caffrey, B.E.; Wels, M.; Joncour, P.; Hughes, S.; Gillet, B.; Kleerebezem, M.; van Hijum, S.A.F.T.; Leulier, F. Nomadic lifestyle of Lactobacillus plantarum revealed by comparative genomics of 54 strains isolated from different habitats. Environ. Microbiol. 2016, 18, 4974–4989. [Google Scholar] [CrossRef]
- Šišić, A.; Baćanović-Šišić, J.; Karlovsky, P.; Wittwer, R.; Walder, F.; Campiglia, E.; Radicetti, E.; Friberg, H.; Baresel, J.P.; Finckh, M.R. Roots of symptom-free leguminous cover crop and living mulch species harbor diverse Fusarium communities that show highly variable aggressiveness on pea (Pisum sativum). PLoS ONE 2018, 13, e0191969. [Google Scholar] [CrossRef]
- Pflughöft, O.; Merker, C.; von Tiedemann, A.; Schäfer, B.C. Zur Verbreitung und Bedeutung von Pilzkrankheiten in Körnerfuttererbsen (Pisum sativum L.) in Deutschland. Gesunde Pflanz 2012, 64, 39–48. [Google Scholar] [CrossRef]
- Eijsink, V.G.H.; Axelsson, L.; Diep, D.B.; Håvarstein, L.S.; Holo, H.; Nes, I.F. Production of class II bacteriocins by lactic acid bacteria; an example of biological warfare and communication. Antonie Van Leeuwenhoek 2002, 81, 639–654. [Google Scholar] [CrossRef]
- Zhao, S.; Hao, X.; Yang, F.; Wang, Y.; Fan, X.; Wang, Y. Antifungal Activity of Lactobacillus plantarum ZZUA493 and Its Application to Extend the Shelf Life of Chinese Steamed Buns. Foods 2022, 11, 195. [Google Scholar] [CrossRef]
- Deepthi, B.V.; Rao, K.P.; Chennapa, G.; Naik, M.K.; Chandrashekara, K.T.; Sreenivasa, M.Y. Antifungal attributes of Lactobacillus plantarum MYS6 against fumonisin producing Fusarium proliferatum associated with poultry feeds. PLoS ONE 2016, 11, e0155122. [Google Scholar] [CrossRef]
- Mani-López, E.; Arrioja-Bretón, D.; López-Malo, A. The impacts of antimicrobial and antifungal activity of cell-free supernatants from lactic acid bacteria in vitro and foods. Compr. Rev. Food Sci. Food Saf. 2022, 21, 604–641. [Google Scholar] [CrossRef]
- Torriani, S.; Felis, G.E.; Dellaglio, F. Differentiation of Lactobacillus plantarum, L. pentosus, and L. paraplantarum by recA Gene Sequence Analysis and Multiplex PCR Assay with recA Gene-Derived Primers. Appl. Environ. Microbiol. 2001, 67, 3450–3454. [Google Scholar] [CrossRef]
- Horváth-Szanics, E.; Perjessy, J.; Klupacs, A.; Takacs, K.; Nagy, A.; Koppany-Szabo, E.; Hegyi, F.; Nemeth-Szerdahelyi, E.; Du, M.Y.; Wang, Z.R.; et al. Study of chitinase and chitinolytic activity of Lactobacillus strains. Acta Aliment. 2020, 49, 214–224. [Google Scholar] [CrossRef]
- Sánchez, B.; Ruiz, L.; Gueimonde, M.; Margolles, A. Omics for the study of probiotic microorganisms. Food Res. Int. 2013, 54, 1061–1071. [Google Scholar] [CrossRef]
- Galloway-Peña, J.R.; Liang, X.; Singh, K.V.; Yadav, P.; Chang, C.; La Rosa, S.L.; Shelburne, S.; Ton-That, H.; Höök, M.; Murray, B.E. The identification and functional characterization of WxL proteins from Enterococcus faecium reveal surface proteins involved in extracellular matrix interactions. J. Bacteriol. 2015, 197, 882–892. [Google Scholar] [CrossRef] [PubMed]
- Visweswaran, G.R.R.; Leenhouts, K.; Van Roosmalen, M.; Kok, J.; Buist, G. Exploiting the peptidoglycan-binding motif, LysM, for medical and industrial applications. Appl. Microbiol. Biotechnol. 2014, 98, 4331–4345. [Google Scholar] [CrossRef] [PubMed]
- Hirozawa, M.T.; Ono, M.A.; Suguiura, I.M.D.S.; Bordini, J.G.; Ono, E.Y.S. Lactic acid bacteria and Bacillus spp. as fungal biological control agents. J. Appl. Microbiol. 2023, 134, lxac083. [Google Scholar] [CrossRef] [PubMed]
- Guimarães, A.; Venancio, A.; Abrunhosa, L. Antifungal effect of organic acids from lactic acid bacteria on Penicillium nordicum. Food Addit. Contam. Part A Chem. Anal. Control. Expo. Risk Assess. 2018, 35, 1803–1818. [Google Scholar] [CrossRef]
- Russo, P.; Arena, M.P.; Fiocco, D.; Capozzi, V.; Drider, D.; Spano, G. Lactobacillus plantarum with broad antifungal activity: A promising approach to increase safety and shelf-life of cereal-based products. Int. J. Food Microbiol. 2017, 247, 48–54. [Google Scholar] [CrossRef]
- Ström, K.; Sjögren, J.; Broberg, A.; Schnürer, J. Lactobacillus plantarum MiLAB 393 produces the antifungal cyclic dipeptides cyclo(L-Phe-L-Pro) and cyclo(L-Phe-trans-4-OH-L-Pro) and 3-phenyllactic acid. Appl. Environ. Microbiol. 2002, 68, 4322–4327. [Google Scholar] [CrossRef]
- Živcović, S.T.; Stošić, S.T.; Ristič, D.T.; Vačurović, I.B.; Stevanović, M.L. The antagonistic potential of Lactobacillus plantarum against some postharvest pathogenic fungi. Zb. Matice Srp. Za Prir. Nauk. 2019, 136, 79–88. [Google Scholar] [CrossRef]

| Accession Number | Isolates Acronym | Organism |
|---|---|---|
| OQ867330 | A | Lactiplantibacillus plantarum |
| OQ867331 | B | Lactiplantibacillus plantarum |
| OQ867332 | C | Lactiplantibacillus plantarum |
| OQ867333 | D | Lactiplantibacillus plantarum |
| OQ867334 | E | Lactiplantibacillus plantarum |
| OQ867335 | I | Lactiplantibacillus plantarum |
| OQ867336 | J | Lactiplantibacillus plantarum |
| OQ867337 | F | Lacticaseibacillus paracasei |
| OQ867338 | G | Lactiplantibacillus pentosus |
| OQ867339 | H | Lactiplantibacillus pentosus |
| OQ867340 | Leuconostoc mesenteroides | |
| OQ867341 | Leuconostoc mesenteroides | |
| OQ867342 | Lactococcus lactis | |
| OQ867343 | Leuconostoc lactis | |
| OQ867344 | Loigolactobacillus coryniformis | |
| OQ867345 | Sporolactobacillus nakayamae | |
| OQ867346 | Leuconostoc mesenteroides | |
| OQ867347 | Leuconostoc mesenteroides | |
| OQ867348 | Leuconostoc mesenteroides | |
| OQ867349 | Leuconostoc mesenteroides | |
| OQ867350 | Leuconostoc citreum | |
| OQ867351 | Lactococcus lactis | |
| OQ867352 | Lactococcus lactis | |
| OQ867353 | Lactococcus lactis | |
| OQ867354 | Lactococcus lactis | |
| OQ867355 | Leuconostoc lactis | |
| OQ867356 | Leuconostoc lactis | |
| OQ867357 | Leuconostoc lactis | |
| OQ867358 | Leuconostoc lactis | |
| OQ867359 | Leuconostoc lactis | |
| OQ867360 | Weissella ceti | |
| OQ954808 | CCDM 1110 | Lactiplantibacillus plantarum |
| OK189680 | CCDM 191 | Lactiplantibacillus plantarum |
| OK189681 | CCDM 196 | Lactiplantibacillus plantarum |
| Species | Acronym | Accession Numbers * | ||
|---|---|---|---|---|
| ITS | Tef1α | Act | ||
| Fusarium proliferatum | CCDBC 349 | OQ923669 | OQ984046 | OQ984055 |
| Fusarium oxysporum | CCDBC 350 | OQ923670 | OQ984047 | OQ984051 |
| Fusarium avenaceum | CCDBC 342 | OQ923671 | OQ984048 | OQ984052 |
| Fusarium culmorum | CCDBC 317 | OQ923672 | OQ984049 | OQ984053 |
| Fusarium sporotrichoides | CCDBC 342 | OQ923673 | OQ984050 | OQ984054 |
| Isolates of Lactobacilli | Bacteriocins Class IIa | |||||
|---|---|---|---|---|---|---|
| Clade 1 | Clade 2 | Clade 4-1 | Clade 4-2 | Clade 5-1 | Clade 5-2 | |
| A | + | − | − | − | + | − |
| B | + | − | − | − | + | − |
| C | + | − | + | − | + | − |
| D | + | − | + | − | + | − |
| E | + | − | + | − | + | Multiple products |
| J | + | − | + | − | + | Multiple products |
| CCDM 191 * | + | + | + | − | + | + |
| CCDM 196 * | + | + | + | − | + | + |
| CCDM 1100 | + | − | + | − | + | Multiple products |
| ATCC14917 * | + | + | + | +150 | + | 500 bp |
| Isolates of Lactobacilli | Gene chiA | LACO CBP |
|---|---|---|
| A | + | − |
| B | + | + |
| C | ++ | − |
| D | + | + |
| E | + | + |
| F | − | − |
| G | + | − |
| H | + | + |
| J | ++ | + |
| CCDM 191 * | ++ | + |
| CCDM 196 * | + | + |
| CCDM 1100 | + | + |
| ATCC14917 | + | + |
| Isolates of Lactobacilli | pH Value | Short-Chain Organic Acids (mg·100 mL−1) | ||
|---|---|---|---|---|
| MRS + FGGM | PDA + 20% CFS | Lactic Acid | Acetic Acid | |
| A | 4.02 | 4.10 | 1342.080 ± 1.52 c | 557.94 ± 0.23 c |
| B | 4.05 | 4.13 | 1299.510 ± 1.23 c | 563.565 ± 1.12 c |
| C | 3.92 | 4.06 | 1331.789 ± 0.85 c | 554.189 ± 0.85 c |
| D | 3.94 | 4.06 | 1296.235 ± 0.78 c | 568.253 ± 0.45 c |
| E | 3.93 | 4.08 | 849.562 ± 1.32 d | 558.877 ± 0.39 c |
| F | 4.19 | 4.32 | 1289.687 ± 1.12 c | 517.792 ± 1.13 c |
| G | 4.07 | 4.12 | 1291.242 ± 0.38 c | 618.808 ± 1.52 b |
| H | 4.06 | 4.12 | 1257.656 ± 1.78 c | 578.871 ± 0.41 c |
| J | 3.88 | 3.98 | 1238.648 ± 1.56 c | 573.299 ± 1.23 c |
| CCDM 191 * | 3.89 | 3.95 | 1739.2 ± 0.22 b | 640.97 ± 0.52 ab |
| CCDM 196 * | 3.92 | 4.04 | 1715.7 ± 0.35 b | 670.90 ± 0.68 ab |
| CCDM 1100 | 3.72 | 3.85 | 2147.5 ± 0.28 a | 707.92 ± 0.23 a |
| MRS + FGGM | 5.6 a | 37.79 ± 0.15 e | 23.2 ± 0.12 d | |
| PDA | 5.5 a | 41.2 ± 0.23 e | 18.5 ± 0.05 d | |
| Statistical parameters | F(13, 320) = 38.6; p ≤ 0.005, N = 14 | F(13, 320) = 56.3; p ≤ 0.001, N = 14 | F(13, 320) = 521.3; p ≤ 0.001, N = 14 | F(13, 320) = 206.7; p ≤ 0.001, N = 14 |
| Factors Tested | DF | F | p |
|---|---|---|---|
| Lactobacilli—isolates (N = 13) | 12 | 8033.013 | 0.001 * |
| Fusarium spp.—isolates (N = 5) | 4 | 65.86 | 0.001 * |
| Lactobacilli vs. Fusarium spp. | 48 | 6.946 | 0.001 * |
| Factors Tested | DF | F | p |
|---|---|---|---|
| Lactobacilli—isolates (N = 13) | 12 | 1165.61 | 0.001 * |
| Fusarium spp.—isolates (N = 5) | 4 | 820.38 | 0.001 * |
| CFSs (N = 2) | 1 | 1438.16 | 0.001 * |
| Lactobacilli vs. Fusarium spp. | 48 | 28.39 | 0.001 * |
| Lactobacilli vs. CFSs | 12 | 189.67 | 0.001 * |
| Fusarium spp. vs. CFSs | 4 | 18.3 | 0.004 * |
| Lactobacilli vs. Fusarium ssp. vs. CFSs | 48 | 14.17 | 0.001 * |
| Factors Tested | DF | F | p |
|---|---|---|---|
| Lactobacilli—isolates (N = 13) | 12 | 1165.61 | 0.001 * |
| Fusarium spp.—isolates (N = 5) | 4 | 820.38 | 0.001 * |
| CFSs (N = 2) | 1 | 14,238.16 | 0.001 * |
| Lactobacilli vs. Fusarium spp. | 48 | 28.39 | 0.001 * |
| Lactobacilli vs. CFSs | 12 | 189.67 | 0.001 * |
| Fusarium spp. vs. CFSs | 4 | 18.3 | 0.001 * |
| Lactobacilli vs. Fusarium ssp. vs. CFSs | 48 | 14.17 | 0.001 * |
| Factors Tested | DF | F | p |
|---|---|---|---|
| Lactobacilli strains (N = 5) | 4 | 820.38 | 0.001 * |
| Fusarium sp. (N = 5) | 4 | 28.39 | 0.001 * |
| Lactobacilli vs. CFS (N = 2) | 1 | 805.00 | 0.001 * |
| LB vs. Fusarium spp. | 16 | 7.94 | 0.001 * |
| LB vs. CFS | 4 | 17.22 | 0.001 * |
Disclaimer/Publisher’s Note: The statements, opinions and data contained in all publications are solely those of the individual author(s) and contributor(s) and not of MDPI and/or the editor(s). MDPI and/or the editor(s) disclaim responsibility for any injury to people or property resulting from any ideas, methods, instructions or products referred to in the content. |
© 2023 by the authors. Licensee MDPI, Basel, Switzerland. This article is an open access article distributed under the terms and conditions of the Creative Commons Attribution (CC BY) license (https://creativecommons.org/licenses/by/4.0/).
Share and Cite
Kavková, M.; Bazalová, O.; Cihlář, J.; Bohatá, A.; Lencová, J.; Konvalina, P. Characterisation of Wild Strains of Lactic Acid Bacteria Isolated from Legumes and Their Biocontrol Potential against Fusarium spp. Agronomy 2023, 13, 2911. https://doi.org/10.3390/agronomy13122911
Kavková M, Bazalová O, Cihlář J, Bohatá A, Lencová J, Konvalina P. Characterisation of Wild Strains of Lactic Acid Bacteria Isolated from Legumes and Their Biocontrol Potential against Fusarium spp. Agronomy. 2023; 13(12):2911. https://doi.org/10.3390/agronomy13122911
Chicago/Turabian StyleKavková, Miloslava, Olga Bazalová, Jaromír Cihlář, Andrea Bohatá, Jana Lencová, and Petr Konvalina. 2023. "Characterisation of Wild Strains of Lactic Acid Bacteria Isolated from Legumes and Their Biocontrol Potential against Fusarium spp." Agronomy 13, no. 12: 2911. https://doi.org/10.3390/agronomy13122911
APA StyleKavková, M., Bazalová, O., Cihlář, J., Bohatá, A., Lencová, J., & Konvalina, P. (2023). Characterisation of Wild Strains of Lactic Acid Bacteria Isolated from Legumes and Their Biocontrol Potential against Fusarium spp. Agronomy, 13(12), 2911. https://doi.org/10.3390/agronomy13122911

